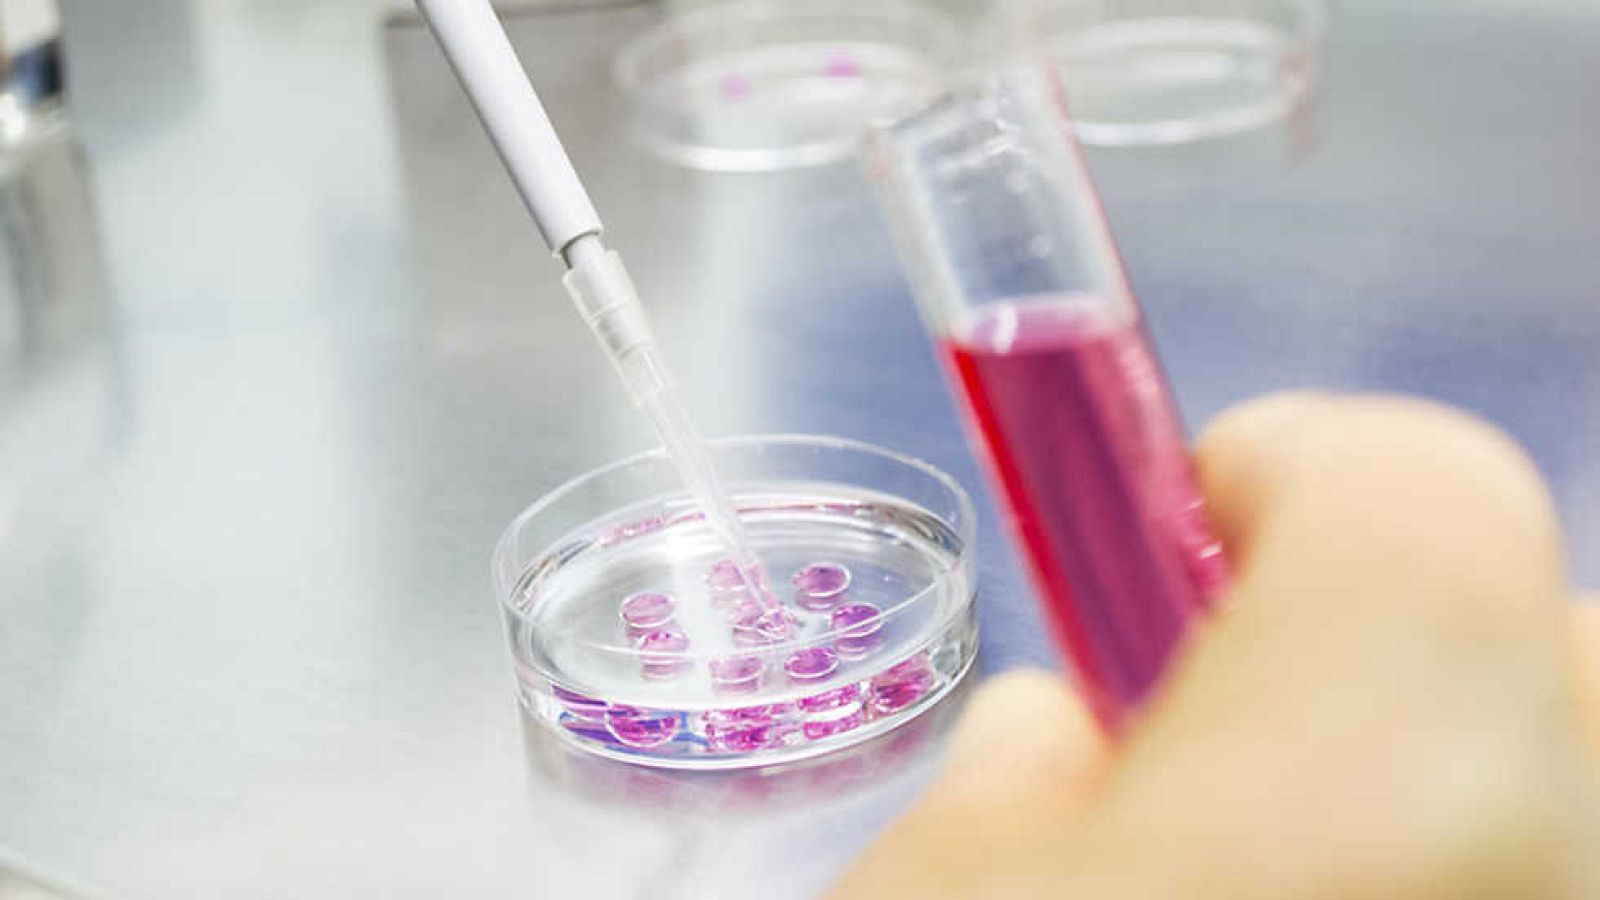
Documenta2 - Nanotecnologías. La Revolución Invisible - ¿Por un planeta más verde? - ver ahora

Documenta2
Nanotecnologías - ¿Por un planeta más verde?
Se supone que la nanotecnología nos ayudará a sanar el planeta en sus diferentes medios: agua, tierra y aire, sin embargo aún no sabemos si...
Disponible hasta: 14-09-2015
07/09/2015 00:49:18